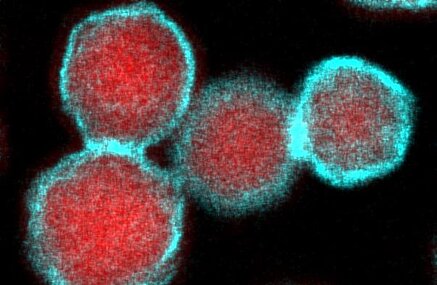

Forschungsbereiche
Die wissenschaftlichen und technologischen Forschungs- und Entwicklungsarbeiten am IOM konzentrieren sich auf vier Forschungsbereiche, welche wir strategisch von den Grundlagen bis zur Anwendung bearbeiten. Ziel ist es, neue Oberflächenfunktionalitäten für zukunftsweisende Anwendungsfelder zu erforschen und zu erschließen.